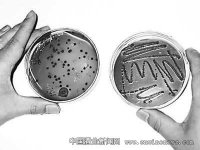

酒企节能减排须保障设备先进性
众所周知,在纯粮固态发酵的白酒生产企业,不锈钢酒甑及冷却器作为必不可少的重要酿酒设备配套使用,缺一不可。酿酒企业要节能减排,稳步提高经济效益和社会效益,就必须保障酒甑及冷却器等重要酿酒设备的先进性、稳定性和安全性。
创新改造
实现酿酒设备升级
如何保障酒甑及冷却器设备的稳定性、先进性和安全性?
笔者认为,酒企工作人员可在生产实践过程中,对酒甑及冷却器等酿酒设备存在的某些弊端,通过实施技改,不断改进和提升其性能。
同时,酒企必须淘汰那些不能让水资源循环利用的冷却器设备,引进可循环利用水资源的先进冷却器设备,为了保障酒甑设备安全性,避免酒醅中的酒精不被发烫的甑体蒸发,建议给酒甑穿上“防热衣”。
在纯粮固态发酵的白酒酿造车间,不锈钢酒甑盖上的通气管与冷却器的制冷内胆入口相连通。发酵好的酒醅蒸馏取酒的过程,即酒醅中所含酒精分子气化后冷凝为酒液的过程。
由于不锈钢酒甑导热快,酒甑外壳受热后极易发烫,这就产生了一个弊端。在酿酒的现场,酿造工通常为了方便自己及上甑人员操作,倒醅时会习惯性地将未取酒的酒醅转到紧贴酒甑处。
成堆的酒醅因紧贴受热后逐渐发烫的不锈钢甑体,必将导致酒醅一起受热,使受热酒醅中少量的酒精分子被蒸发掉,造成浪费。若是酿造工倒醅时,刻意让酒醅与酒甑保持适当间距,这样又会给上甑馏酒人员操作带来不便。再者,酿造工上甑操作时,身体长时间贴近发烫的酒甑,则会有害身体健康。
节能减排
保证酿酒质量
要想解决上述问题,需给不锈钢酒甑穿上一件“防热衣”。具体的实施方法是:在不锈钢酒甑的甑体上箍一圈厚度合适的木板或竹帘子,进行隔热。为了便于酒醅取酒完毕后能顺利地开栓出甑进行摊晾下曲,维修工在给甑体箍木板或竹帘子时,须在酒甑的两个甑栓处各留一个小缺口。
为了保障酒甑设备先进性和稳定性,建议给甑锅内的输气系统安装“稳定器”。例如,以多轮投料多轮酿造取酒的固态发酵白酒企业的生产工艺为例,随着酿酒轮次逐步深入,酒醅水分会逐步增大。这样一来,酿造工面对日益湿重的酒醅,在上甑馏酒操作过程中,稍有不慎就会造成酒醅偏气、塌气等现象发生,从而影响酒醅顺利馏酒,减少酒醅本身的出酒率。
虽说酿造工艺明确规定,上甑馏酒人员在操作时须做到“轻、薄、匀、快、准”,探气上甑,见湿压气,做到不塌气,不跑气,不偏气,避免因操作不当,致使酒醅蒸馏不畅,影响酒醅本身的出酒率。然而,因现今许多不锈钢酒甑甑锅内的输气系统在设计上本身存在缺陷,其输气系统工作稳定性不强,使得酿造工在上甑操作过程中稍有不慎,就极易导致酒醅因偏气、塌气而造成馏酒不畅,最终导致减少酒醅本身的出酒率、损失原酒产量的现象时有发生。
若是在酒甑锅内输气系统实施小技改,给甑锅内输气系统安装一个“稳定器”,以此增强酒甑输气系统稳定性。通过在白云边酿造车间的实践证明,只要对酒甑甑锅内输气管道实施小技改,可明显改善酒甑输气系统的工作稳定性,为酿酒班每天顺利馏酒提供重要的设备保障。
对酒甑锅内输气系统的具体改进方法:由维修工精心制作一个直径约0.5米、且布满小孔的不锈钢圆盘(建议以不锈钢旧酒甑底为原材料),再将三个金属支架竖立焊接固定在甑锅底部,而后将不锈钢圆盘平稳地焊接固定到金属支架上,做到不锈钢圆盘与甑锅内输气管口呈水平状即可。
事实上,焊接在甑锅内输气管道和三角金属支架上的不锈钢圆盘,恰好充当了酒甑输气系统的“稳定器”,可确保酒甑输气管道输出的蒸气均匀而稳定,方便酿造工上甑蒸酒。
酿酒冷却器设备接酒管须采用不锈钢管或竹管。有个细节酿酒企业须注意:与酒甑设备配套使用的冷却器设备上的接酒管道,切不可采用塑胶管等易腐材料,须选用空心不锈钢管或竹管等无毒副作用的材料做接酒管。因为塑胶管极易被酒酸腐蚀,久而久之那种刺鼻的胶泥味易带入原酒中,影响原酒味道和质量。
理论指导实践
推动生态酿酒
为了切实搞好节能减排,增加经济效益和社会效益,酿酒企业须保障冷却器设备的先进性。现今有些酿酒企业的冷却器设备性能比较落后,主要表现在酿酒所用的冷却水不能循环利用,冷却器馏酒后的热水直接排入了下水道。既造成极大的水资源浪费,增加了酿酒成本,增加企业治污达标排放成本。
前几年,一篇题为《酿酒行业节能节水方法及其软化水冷却器》的文章,详细介绍了一种酿酒行业节能节水的方法和装置。该方法可以把锅炉软化水或强磁软化水先作为冷却水使用后,再把高温冷却水作为锅炉用水使用。同时提高冷却器的冷却效率,达到节煤节水和节电的目的。据悉,该先进冷却器设备已在许多酿酒企业投入使用,效果很好。有利于实现酿酒企业节能减排,生态酿酒,保护环境。
《酿酒冷却水循环利用方法及其装置》一文核心提示:本发明提供了一种酿酒冷却水循环利用方法,是将自然水进行软化处理后用于酿酒蒸馏时的冷凝水,蒸馏酒后的热水经冷却后循环、重复使用。酿酒冷却水循环利用的装置,包括采用PC中央控制台及其控制线路分别与软水处理装置、热水循环冷却装置、冷却器控制连接,即软水处理装置的冷水通过冷水管道分别与储备箱、各酿酒冷却器连通,酿酒蒸馏后的热水通过热水管道与热水循环冷却装置的回收箱连通。
该发明的有益效果是,该方法和装置通过在一些酒厂试验表明,将冷却水循环重复使用,可以达到废水零排放;同时可保证酿酒冷凝酒温最佳温度,确保酒品的质量。
转载此文章请注明文章来源《华夏酒报》。